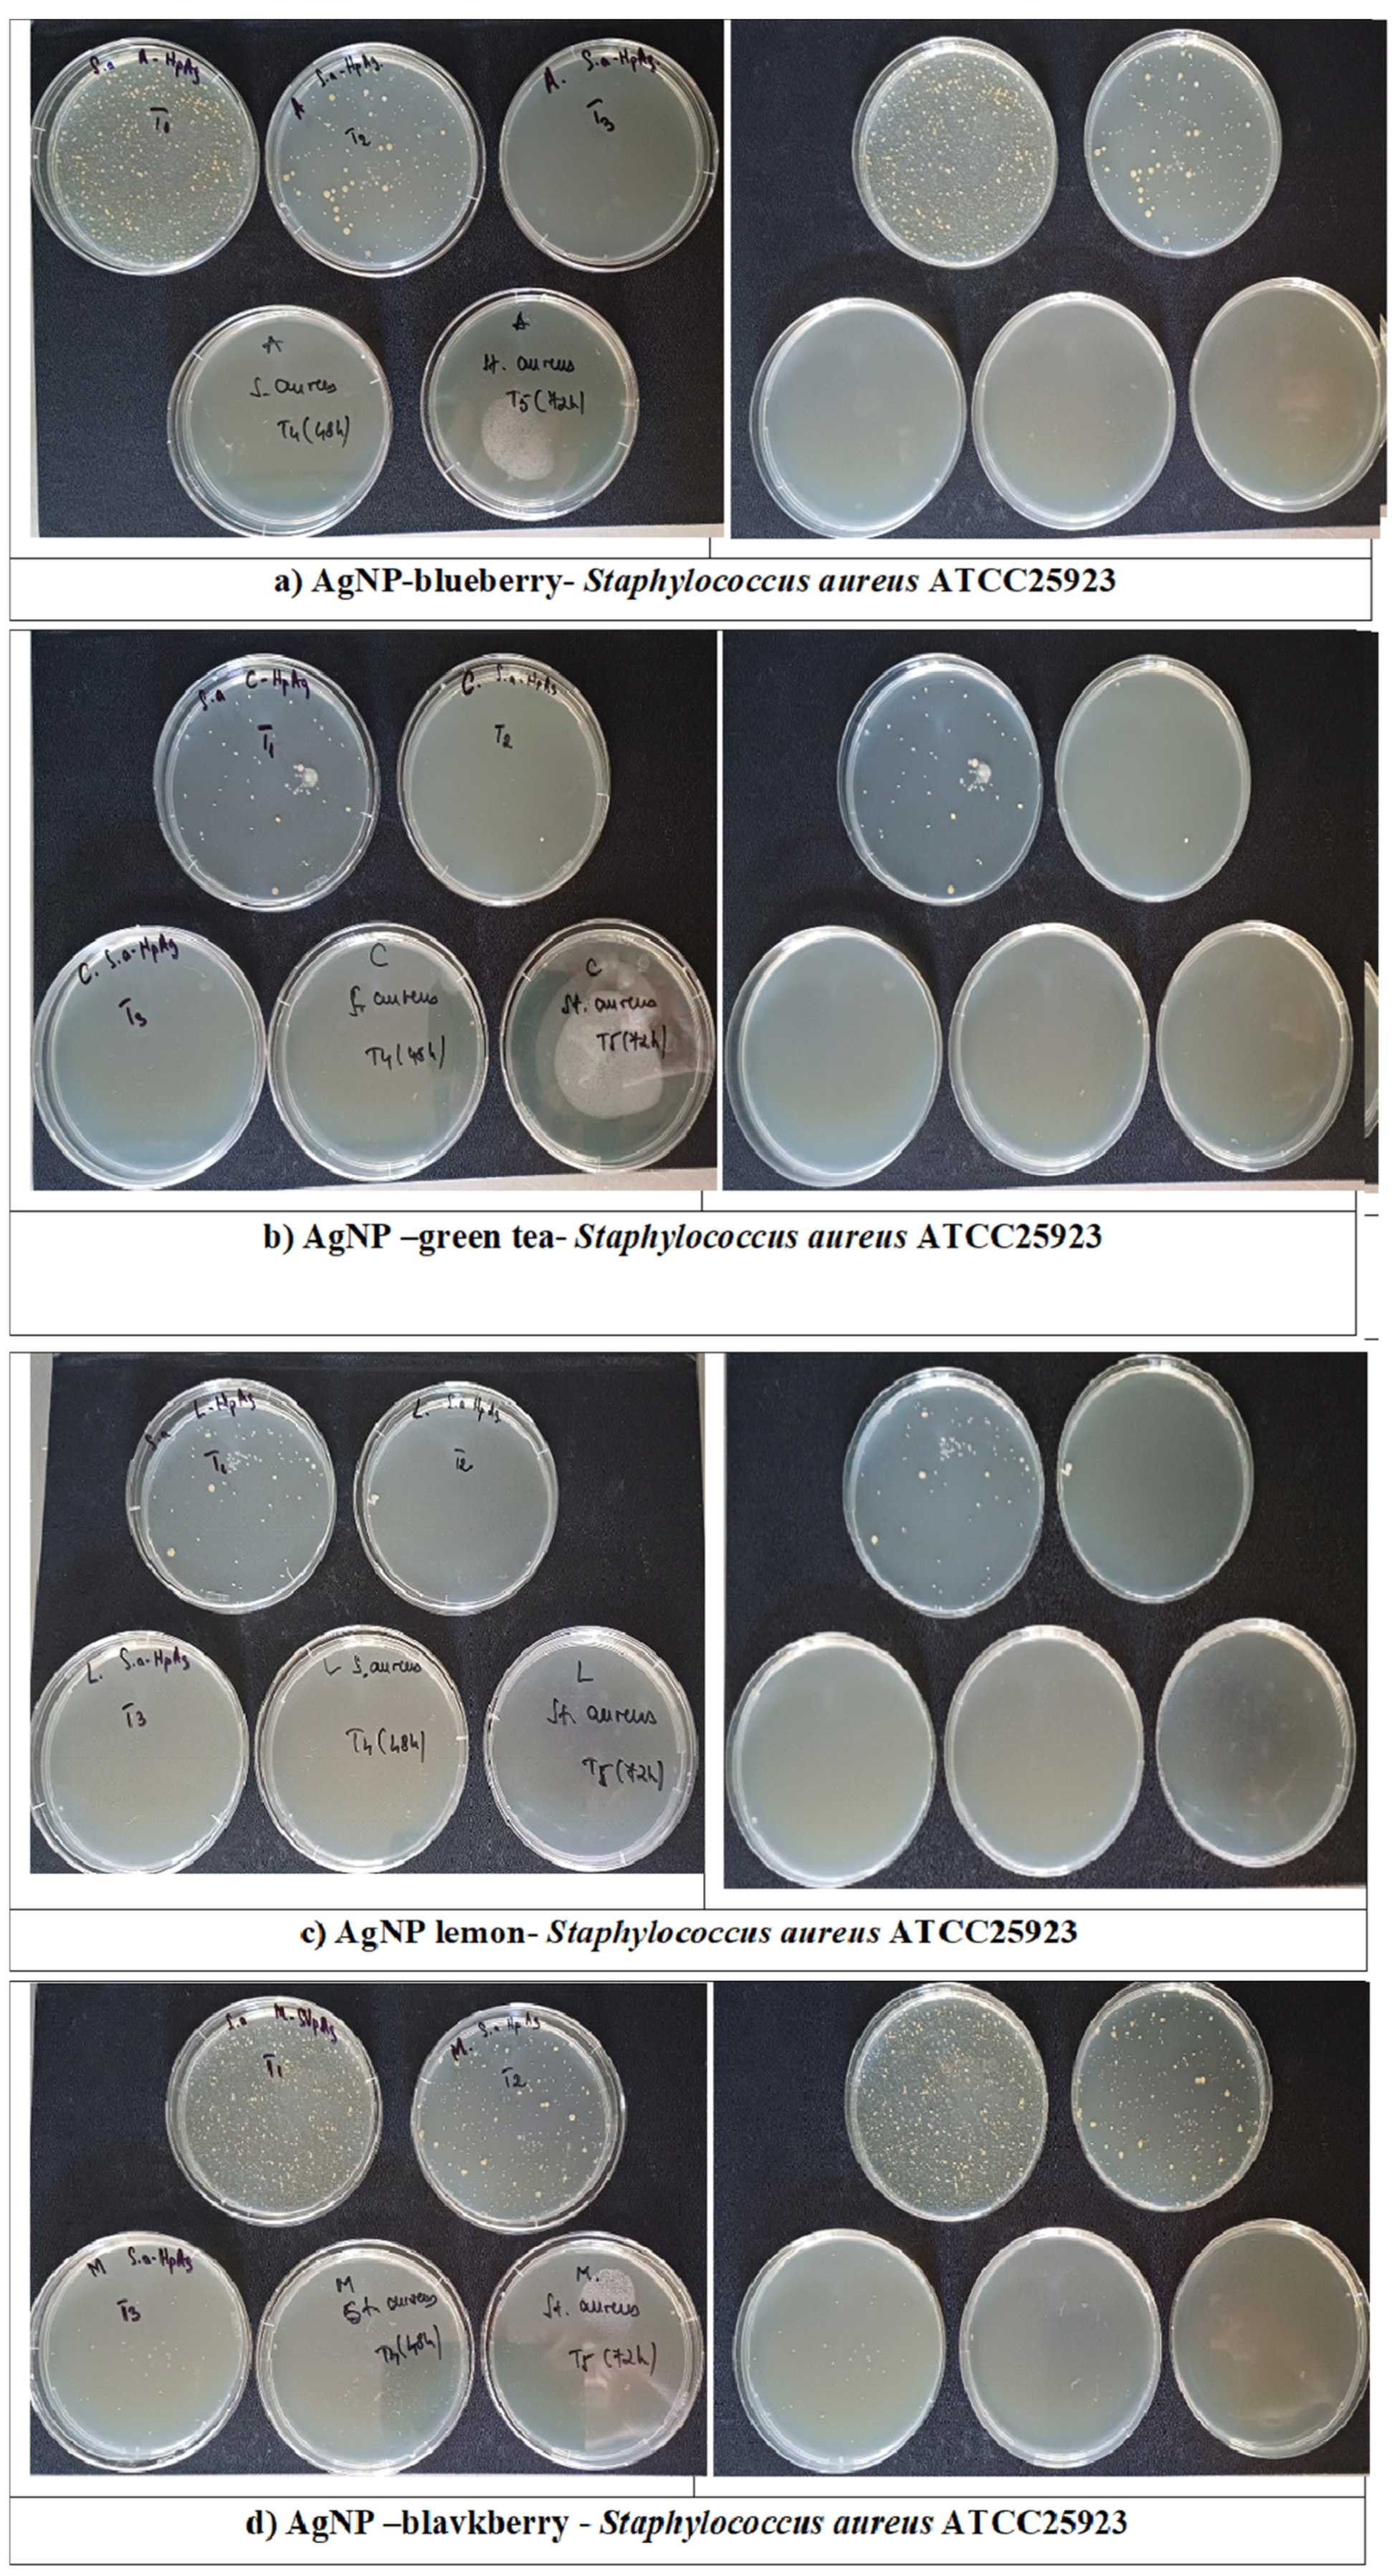
Sustainability 17 05321 g016a Sustainability 17 05321 g016a

Eco-Friendly Synthesis of Silver Nanoparticles with Significant Antimicrobial Activity for Sustainable Applications
Abstract
1. Introduction
2. Materials and Methods
2.1. Materials
2.2. Silver Reduction with Lemon Extract
2.3. Silver Reduction with Green Tea Extract
2.4. Silver Reduction with Blueberry Extract and Blackberry Extract
2.5. Fruit Extract for Antioxidant Capacity Assay
2.6. Total Polyphenol Content
2.7. Total Flavone Content
2.8. Total Antioxidant Capacity
2.9. Characterization Methods
2.10. Antibacterial Activity of AgNPs on Bacteria
3. Results
3.1. Antioxidant Properties of Vegetal Extracts
3.2. Spectral and Optical Characterization
3.3. Results of Microscopy Investigation
3.4. Results of Crystallinity Analysis
3.5. Results of Hydrodynamic Diameter and Zeta Potential Measurement
3.6. The Results of Antimicrobial Activity Tests
3.6.1. The Results of Agar Diffusion Method Application
3.6.2. The Results of the Kill-Time Test Application
4. Discussion
5. Conclusions
Author Contributions
Funding
Institutional Review Board Statement
Informed Consent Statement
Data Availability Statement
Conflicts of Interest
References
- Yaqoob, A.A.; Umar, K.; Ibrahim, M.N.M. Silver nanoparticles: Various methods of synthesis, size affecting factors and their potential applications—A review. Appl. Nanosci. 2020, 10, 1369–1378. [Google Scholar] [CrossRef]
- Prasad, R.; Deena, S.; Rajesh, C.; Pandit, V.K.; Pathan, H.M. Employing green synthesized silver nanoparticles as light harvesters in nanostructured solar cells. J. Renew. Sustain. Energy 2013, 5, 031615. [Google Scholar] [CrossRef]
- Kalfagiannis, N.; Karagiannidis, P.G.; Pitsalidis, C.; Panagiotopoulos, N.T.; Gravalidis, C.; Kassavetis, S.; Patsalas, P.; Logothetidis, S. Plasmonic silver nanoparticles for improved organic solar cells. Sol. Energy Mater. Sol. Cells 2012, 104, 165–174. [Google Scholar] [CrossRef]
- Walshe, J.; Carron, P.M.; McLoughlin, C.; McCormack, S.; Doran, J.; Amarandei, G. Nanofluid development using silver nanoparticles and organic-luminescent molecules for solar-thermal and hybrid photovoltaic-thermal applications. Nanomaterials 2020, 10, 1201. [Google Scholar] [CrossRef]
- Khan, S.A.; Jain, M.; Pandey, A.; Pant, K.K.; Ziora, Z.M.; Blaskovich, M.A.; Aminabhavi, T.M. Leveraging the potential of silver nanoparticles-based materials towards sustainable water treatment. J. Environ. Manag. 2022, 319, 115675. [Google Scholar] [CrossRef]
- Rostami-Vartooni, A.; Nasrollahzadeh, M.; Alizadeh, M. Green synthesis of seashell supported silver nanoparticles using Bunium persicum seeds extract: Application of the particles for catalytic reduction of organic dyes. J. Colloid Interface Sci. 2016, 470, 268–275. [Google Scholar] [CrossRef]
- Atarod, M.; Nasrollahzadeh, M.; Sajadi, S.M. Euphorbia heterophylla leaf extract mediated green synthesis of Ag/TiO2 nanocomposite and investigation of its excellent catalytic activity for reduction of variety of dyes in water. J. Colloid Interface Sci. 2016, 452, 272–279. [Google Scholar] [CrossRef]
- Zahran, M.; Khalifa, Z.; Zahran, M.A.H.; Azzem, M.A. Recent advances in silver nanoparticle-based electrochemical sensors for determining organic pollutants in water: A review. Mater. Adv. 2021, 2, 7350–7365. [Google Scholar] [CrossRef]
- Abbas, A.; Amin, H.M. Silver nanoparticles modified electrodes for electroanalysis: An updated review and a perspective. Microchem. J. 2022, 175, 107166. [Google Scholar] [CrossRef]
- Ivanišević, I. The role of silver nanoparticles in electrochemical sensors for aquatic environmental analysis. Sensors 2023, 23, 3692. [Google Scholar] [CrossRef]
- Roy, B.; Bairi, P.; Nandi, A.K. Selective colorimetric sensing of mercury(ii) using turn off–turn on mechanism from riboflavin stabilized silver nanoparticles in aqueous medium. Analyst 2011, 136, 3605. [Google Scholar] [CrossRef] [PubMed]
- Fernández-Lodeiro, J.; Núñez, C.; Oliveira, E.; Capelo, J.L.; Lodeiro, C. 1D chain fluorescein-functionalized gold and silver nanoparticles as new optical mercury chemosensor in aqueous media. J. Nanopart. Res. 2013, 15, 1828. [Google Scholar] [CrossRef]
- Lee, D.K.; Kang, Y.S. Synthesis of silver nanocrystallites by a new thermal decomposition method and their characterization. ETRI J. 2004, 26, 252–256. [Google Scholar] [CrossRef]
- Boutinguiza, M.; Comesaña, R.; Lusquiños, F.; Riveiro, A.; Del Val, J.; Pou, J. Production of silver nanoparticles by laser ablation in open air. Appl. Surf. Sci. 2015, 336, 108–111. [Google Scholar] [CrossRef]
- Tsuji, T.; Iryo, K.; Watanabe, N.; Tsuji, M. Preparation of silver nanoparticles by laser ablation in solution: Influence of laser wavelength on particle size. Appl. Surf. Sci. 2002, 202, 80–85. [Google Scholar] [CrossRef]
- Mavani, K.; Shah, M. Synthesis of silver nanoparticles by using sodium borohydride as a reducing agent. Int. J. Eng. Res. Technol. 2013, 2, 1–5. [Google Scholar]
- Dasaradhudu, Y.; Srinivasan, M.A. Synthesis and characterization of silver nano particles using co-precipitation method. Mater. Today Proc. 2020, 33, 720–723. [Google Scholar] [CrossRef]
- Ivask, A.; Kurvet, I.; Kasemets, K.; Blinova, I.; Aruoja, V.; Suppi, S.; Vija, H.; Käkinen, A.; Titma, T.; Heinlaan, M.; et al. Size-dependent toxicity of silver nanoparticles to bacteria, yeast, algae, crustaceans and mammalian cells in vitro. PLoS ONE 2014, 9, e102108. [Google Scholar] [CrossRef]
- Singh, R.; Shedbalkar, U.U.; Wadhwani, S.A.; Chopade, B.A. Bacteriagenic silver nanoparticles: Synthesis, mechanism, and applications. Appl. Microbiol. Biotechnol. 2015, 99, 4579–4593. [Google Scholar] [CrossRef]
- Al-Asbahi, M.G.; Al-Ofiry, B.A.; Saad, F.A.; Alnehia, A.; Al-Gunaid, M.Q. Silver nanoparticles biosynthesis using mixture of Lactobacillus sp. and Bacillus sp. growth and their antibacterial activity. Sci. Rep. 2024, 14, 10224. [Google Scholar] [CrossRef]
- Alsamhary, K.I. Eco-friendly synthesis of silver nanoparticles by Bacillus subtilis and their antibacterial activity. Saudi J. Biol. Sci. 2020, 27, 2185–2191. [Google Scholar] [CrossRef]
- Yassin, M.A.; Elgorban, A.M.; El-Samawaty, A.E.R.M.; Almunqedhi, B.M. Biosynthesis of silver nanoparticles using Penicillium verrucosum and analysis of their antifungal activity. Saudi J. Biol. Sci. 2021, 28, 2123–2127. [Google Scholar] [CrossRef] [PubMed]
- Guilger-Casagrande, M.; Lima, R.D. Synthesis of silver nanoparticles mediated by fungi: A review. Front. Bioeng. Biotechnol. 2019, 7, 287. [Google Scholar] [CrossRef] [PubMed]
- Wang, D.; Xue, B.; Wang, L.; Zhang, Y.; Liu, L.; Zhou, Y. Fungus-mediated green synthesis of nano-silver using Aspergillus sydowii and its antifungal/antiproliferative activities. Sci. Rep. 2021, 11, 10356. [Google Scholar] [CrossRef] [PubMed]
- Song, J.Y.; Kim, B.S. Rapid biological synthesis of silver nanoparticles using plant leaf extracts. Bioprocess Biosyst. Eng. 2009, 32, 79–84. [Google Scholar] [CrossRef]
- Logeswari, P.; Silambarasan, S.; Abraham, J. Synthesis of silver nanoparticles using plant extracts and analysis of their antimicrobial property. J. Saudi Chem. Soc. 2015, 19, 311–317. [Google Scholar] [CrossRef]
- Ahmed, S.; Ahmad, M.; Swami, B.L.; Ikram, S. Green synthesis of silver nanoparticles using Azadirachta indica aqueous leaf extract. J. Rad. Res. Appl. Sci. 2016, 9, 1–7. [Google Scholar] [CrossRef]
- Vanlalveni, C.; Lallianrawna, S.; Biswas, A.; Selvaraj, M.; Changmai, B.; Rokhum, S.L. Green synthesis of silver nanoparticles using plant extracts and their antimicrobial activities: A review of recent literature. RSC Adv. 2021, 11, 2804–2837. [Google Scholar] [CrossRef]
- Abada, E.; Mashraqi, A.; Modafer, Y.; Al Abboud, M.A.; El-Shabasy, A. Review green synthesis of silver nanoparticles by using plant extracts and their antimicrobial activity. Saudi J. Biol. Sci. 2024, 31, 103877. [Google Scholar] [CrossRef]
- Goswami, S.R.; Sahareen, T.; Singh, M.; Kumar, S. Role of biogenic silver nanoparticles in disruption of cell–cell adhesion in Staphylococcus aureus and Escherichia coli biofilm. J. Ind. Eng. Chem. Res. 2015, 26, 73–80. [Google Scholar] [CrossRef]
- Ali, S.G.; Jalal, M.; Ahmad, H.; Sharma, D.; Ahmad, A.; Umar, K.; Khan, H.M. Green synthesis of silver nanoparticles from Camellia sinensis and its antimicrobial and antibiofilm effect against clinical isolates. Materials 2022, 15, 6978. [Google Scholar] [CrossRef] [PubMed]
- Widatalla, H.A.; Yassin, L.F.; Alrasheid, A.A.; Ahmed, S.A.R.; Widdatallah, M.O.; Eltilib, S.H.; Mohamed, A.A. Green synthesis of silver nanoparticles using green tea leaf extract, characterization and evaluation of antimicrobial activity. Nanoscale Adv. 2022, 4, 911–915. [Google Scholar] [CrossRef]
- Wirwis, A.; Sadowski, Z. Green synthesis of silver nanoparticles: Optimizing green tea leaf extraction for enhanced physicochemical properties. ACS Omega 2023, 8, 30532–30549. [Google Scholar] [CrossRef]
- Kahrilas, G.A.; Wally, L.M.; Fredrick, S.J.; Hiskey, M.; Prieto, A.L.; Owens, J.E. Microwave-assisted green synthesis of silver nanoparticles using orange peel extract. ACS Sustain. Chem. Eng. 2014, 2, 367–376. [Google Scholar] [CrossRef]
- Alkhulaifi, M.M.; Alshehri, J.H.; Alwehaibi, M.A.; Awad, M.A.; Al-Enazi, N.M.; Aldosari, N.S.; Ashraf, A. Green synthesis of silver nanoparticles using Citrus limon peels and evaluation of their antibacterial and cytotoxic properties. Saudi J. Biol. Sci. 2020, 27, 3434–3441. [Google Scholar] [CrossRef]
- Mickky, B.; Elsaka, H.; Abbas, M.; Gebreil, A.; Shams Eldeen, R. Orange peel-mediated synthesis of silver nanoparticles with antioxidant and antitumor activities. BMC Biotechnol. 2024, 24, 66. [Google Scholar] [CrossRef]
- Kalia, A.; Manchanda, P.; Bhardwaj, S.; Singh, G. Biosynthesized silver nanoparticles from aqueous extracts of sweet lime fruit and callus tissues possess variable antioxidant and antimicrobial potentials. Inorg. Nano-Met. Chem. 2020, 50, 1053–1062. [Google Scholar] [CrossRef]
- Kumar, D.; Sharma, N. Green chemistry approach: Synthesis of silver nanoparticles by using lime juice (Citrus aurantifolia) extract and their evaluation as antibacterial agent. J. Indian Chem. Soc. 2014, 91, 1667–1674. [Google Scholar]
- Abdelrazik, M.; Elkotaby, H.H.; Yousef, A.; El-Sayed, A.F.; Khedr, M. Green synthesis of silver nanoparticles derived from lemon and pomegranate peel extracts to combat multidrug-resistant bacterial isolates. J. Genet. Eng. Biotechnol. 2023, 21, 97. [Google Scholar] [CrossRef]
- Rizwana, H.; Alwhibi, M.S.; Al-Judaie, R.A.; Aldehaish, H.A.; Alsaggabi, N.S. Sunlight-mediated green synthesis of silver nanoparticles using the berries of Ribes rubrum (red currants): Characterisation and evaluation of their antifungal and antibacterial activities. Molecules 2022, 27, 2186. [Google Scholar] [CrossRef]
- Umoren, S.A.; Nzila, A.M.; Sankaran, S.; Solomon, M.M.; Umoren, P.S. Green synthesis, characterization and antibacterial activities of silver nanoparticles from strawberry fruit extract. Pol. J. Chem. Technol. 2017, 19, 128–136. [Google Scholar] [CrossRef]
- Stevanović, M.S.; Zvezdanović, J.B.; Stanojević, L.P.; Stanojević, J.S.; Petrović, S.M.; Cakić, M.D.; Cvetković, D.J. Synthesis, characterization and antioxidant activity of silver nanoparticles stabilized by aqueous extracts of wild blackberry (Rubus spp.) and raspberry (Rubus idaeus L.) leaves. Adv. Technol. 2019, 8, 47–58. [Google Scholar] [CrossRef]
- Nadagouda, M.N.; Iyanna, N.; Lalley, J.; Han, C.; Dionysiou, D.D.; Varma, R.S. Synthesis of silver and gold nanoparticles using antioxidants from blackberry, blueberry, pomegranate, and turmeric extracts. ACS Sustain. Chem. Eng. 2014, 2, 1717–1723. [Google Scholar] [CrossRef]
- Niluxsshun, M.C.D.; Masilamani, K.; Mathiventhan, U. Green synthesis of silver nanoparticles from the extracts of fruit peel of Citrus tangerina, Citrus sinensis, and Citrus limon for antibacterial activities. Bioinorg. Chem. Appl. 2021, 2021, 6695734. [Google Scholar] [CrossRef] [PubMed]
- Khane, Y.; Benouis, K.; Albukhaty, S.; Sulaiman, G.M.; Abomughaid, M.M.; Al Ali, A.; Dizge, N. Green synthesis of silver nanoparticles using aqueous Citrus limon zest extract: Characterization and evaluation of their antioxidant and antimicrobial properties. Nanomaterials 2022, 12, 2013. [Google Scholar] [CrossRef]
- Demirbas, A.; Yilmaz, V.; Ildiz, N.; Baldemir, A.; Ocsoy, I. Anthocyanins-rich berry extracts directed formation of Ag NPs with the investigation of their antioxidant and antimicrobial activities. J. Mol. Liq. 2017, 248, 1044–1049. [Google Scholar] [CrossRef]
- Dhulappanavar, G.; Hungund, B.; Ayachit, N.; Bhakat, A.; Singh, P.P.; Priya, S.; Pawar, J.; Vinchurkar, P.; Henry, R. Characterization of silver nanoparticles biosynthesized using lemon juice. In Proceedings of the International Conference on Nanoscience, Engineering and Technology (ICONSET 2011), Chennai, India, 28–30 November 2011; pp. 258–262. [Google Scholar]
- Nakhjavani, M.; Nikkhah, V.; Sarafraz, M.M.; Shoja, S.; Sarafraz, M. Green synthesis of silver nanoparticles using green tea leaves: Experimental study on the morphological, rheological and antibacterial behaviour. Heat and Mass Transf. 2017, 53, 3201–3209. [Google Scholar] [CrossRef]
- Li, K.; Ma, C.; Jian, T.; Sun, H.; Wang, L.; Xu, H.; Cheng, X. Making good use of the byproducts of cultivation: Green synthesis and antibacterial effects of silver nanoparticles using the leaf extract of blueberry. J. Food Sci. Technol. 2017, 54, 3569–3576. [Google Scholar] [CrossRef]
- Kumar, B.; Smita, K.; Cumbal, L.; Debut, A. Green synthesis of silver nanoparticles using Andean blackberry fruit extract. Saudi J. Biol. Sci. 2017, 24, 45–50. [Google Scholar] [CrossRef]
- Singleton, V.L.; Orthofer, R.; Lamuela-Raventós, R.M. Analysis of total phenols and other oxidation substrates and antioxidants by means of Folin-Ciocalteu reagent. In Methods in Enzymology, 1st ed.; Packer, L., Ed.; Elsevier: Cambridge, MA, USA, 1999; Volume 299, pp. 152–178. [Google Scholar]
- Dewanto, V.; Wu, X.; Adom, K.K.; Liu, R.H. Thermal processing enhances the nutritional value of tomatoes by increasing total antioxidant activity. J. Agric. Food Chem. 2002, 50, 3010–3014. [Google Scholar] [CrossRef]
- Molyneux, P. The use of the stable free radical diphenylpicrylhydrazyl (DPPH) for estimating antioxidant activity. Songklanakarin J. Sci. Technol. 2004, 26, 211–219. [Google Scholar]
- Bonev, B.; Hooper, J.; Parisot, J. Principles of assessing bacterial susceptibility to antibiotics using the agar diffusion method. J. Antimicrob. Chemother 2008, 61, 1295–1301. [Google Scholar] [CrossRef] [PubMed]
- Demirel Bayik, G.; Baykal, B. Impact of Plant Species on the Synthesis and Characterization of Biogenic Silver Nanoparticles: A Comparative Study of Brassica oleracea, Corylus avellana, and Camellia sinensis. Nanomaterials 2024, 14, 1954. [Google Scholar] [CrossRef] [PubMed]
- Lima, B.G.A.; Silva, R.R.; Meira, H.M.; Durval, I.J.B.; Macedo Bezerra Filho, C.; Silva, T.A.L.; Sarubbo, L.A.; Luna, J.M. Synthesis and Characterization of Silver Nanoparticles Stabilized with Biosurfactant and Application as an Antimicrobial Agent. Microorganisms 2024, 12, 1849. [Google Scholar] [CrossRef]
- Gil-Martínez, L.; Mut-Salud, N.; Ruiz-García, J.A.; Falcón-Piñeiro, A.; Maijó-Ferré, M.; Baños, A.; Gómez-Caravaca, A.M. Phytochemicals determination, and antioxidant, antimicrobial, anti-inflammatory and anticancer activities of blackberry fruits. Foods 2023, 12, 1505. [Google Scholar] [CrossRef]
- Li, D.; Li, B.; Ma, Y.; Sun, X.; Lin, Y.; Meng, X. Polyphenols, anthocyanins, and flavonoids contents and the antioxidant capacity of various cultivars of highbush and half-high blueberries. J. Food Compos. Anal. 2017, 62, 84–93. [Google Scholar] [CrossRef]
- Okan, O.T.; Deniz, I.; Yayli, N.; Sat, I.G.; Oz, M.; Hatipoglu Serdar, G. Antioxidant activity, sugar content and phenolic profiling of blueberries cultivars: A comprehensive comparison. Not. Bot. Horti. Agrobo. Cluj-Napoca 2018, 46, 639–652. [Google Scholar] [CrossRef]
- Castrejon, A.D.R.; Eichholz, I.; Rohn, S.; Kroh, L.W.; Huyskens-Keil, S. Phenolic profile and antioxidant activity of highbush blueberry (Vaccinium corymbosum L.) during fruit maturation and ripening. Food Chem. 2008, 109, 564–572. [Google Scholar] [CrossRef]
- Koczka, N.; Stefanovits-Banyai, E.; Prokaj, E. Element composition, total phenolics and antioxidant activity of wild and cultivated blackberry (Rubus fruticosus L.) fruits and leaves during the harvest time. Not. Bot. Horti. Agrobo. Cluj-Napoca 2018, 46, 563–569. [Google Scholar] [CrossRef]
- Gorinstein, S.; Martín-Belloso, O.; Park, Y.S.; Haruenkit, R.; Lojek, A.; Číž, M.; Trakhtenberg, S. Comparison of some biochemical characteristics of different citrus fruits. Food Chem. 2001, 74, 309–315. [Google Scholar] [CrossRef]
- Zhao, C.N.; Tang, G.Y.; Cao, S.Y.; Xu, X.Y.; Gan, R.Y.; Liu, Q.; Mao, Q.Q.; Shang, A.; Li, H.B. Phenolic profiles and antioxidant activities of 30 tea infusions from green, black, oolong, white, yellow, and dark teas. Antioxidants 2019, 8, 215. [Google Scholar] [CrossRef] [PubMed]
- Xu, G.; Liu, D.; Chen, J.; Ye, X.; Ma, Y.; Shi, J. Juice components and antioxidant capacity of citrus varieties cultivated in China. Food Chem. 2008, 106, 545–551. [Google Scholar] [CrossRef]
- Celant, V.M.; Braga, G.C.; Vorpagel, J.A.; Salibe, A.B. Phenolic composition and antioxidant capacity of aqueous and ethanolic extracts of blackberries. Rev. Bras. Frutic. 2016, 38, e-411. [Google Scholar] [CrossRef][Green Version]
- Vinci, G.; D’Ascenzo, F.; Maddaloni, L.; Prencipe, S.A.; Tiradritti, M. The influence of green and black tea infusion parameters on total polyphenol content and antioxidant activity by ABTS and DPPH assays. Beverages 2022, 8, 18. [Google Scholar] [CrossRef]
- Garcia-Nicolas, M.; Ledesma-Escobar, C.A.; Priego-Capote, F. Spatial Distribution and Antioxidant Activity of Extracts from Citrus Fruits. Antioxidants 2023, 12, 781. [Google Scholar] [CrossRef]
- Prathna, T.C.; Chandrasekaran, N.; Raichur, A.M.; Mukherjee, A. Biomimetic synthesis of silver nanoparticles by Citrus limon (lemon) aqueous extract and theoretical prediction of particle size. Colloids Surf. B Biointerfaces. 2011, 82, 152–159. [Google Scholar] [CrossRef] [PubMed]
- Hasan, W.L.; Sari, R.; Hendradi, E. Green synthesis of antimicrobial silver nanoparticles using green tea extract: The role of concentration and pH. J. Sains Farm. Klin. 2024, 11, 25–31. [Google Scholar] [CrossRef]
- Ildiz, N.; Korkmaz, F.; Yusufbeyoğlu, S.; Kilic, A.B.; Ocsoy, İ. Silver nanoparticles biosynthesized from Vaccinium myrtillus L. against multiple antibiotic resistance and biofilm forming Escherichia coli and Pseudomonas aeruginosa. Indian J. Pharm. Educ. Res. 2021, 55, 5220–5224. [Google Scholar] [CrossRef]
- Cullity, B.D.; Stock, S.R. Pearson. Elements of X-Ray Diffraction, 3rd ed.; Pearson Education Limited: Harlow, UK, 2001. [Google Scholar]
- Koch, W.; Kukula-Koch, W.; Komsta, Ł.; Marzec, Z.; Szwerc, W.; Głowniak, K. Green tea quality evaluation based on its catechins and metals composition in combination with chemometric analysis. Molecules 2018, 23, 1689. [Google Scholar] [CrossRef]
- Minea, B.B.; Radulescu, C.; Dulama, I.D.; Banica, A.L.; Stirbescu, R.M.; Stanescu, S.G. Determination of heavy metals content from citrus fruit peels. J. Sci. Arts 2024, 24, 725–734. [Google Scholar] [CrossRef]
- Rahim, M.; Saqib, N.U.; Wahid, F.; Khan, N.; Alrawi, L.I. Analysis of toxic heavy metal content of the most widely consumed fruits. J. Phys. Sci. 2020, 31, 61–73. [Google Scholar] [CrossRef]
- Czech, A.; Zarycka, E.; Yanovych, D.; Zasadna, Z.; Grzegorczyk, I.; Kłys, S. Mineral content of the pulp and peel of various citrus fruit cultivars. Biol. Trace Elem. Res. 2020, 193, 555–563. [Google Scholar] [CrossRef] [PubMed]
- Warczyk, A.; Gruba, P.; Józefowska, A.; Wanic, T.; Warczyk, A.; Świątek, B.; Pietrzykowski, M. Accumulation of heavy metals in blueberry (Vaccinium myrtillus L.) and dominant mosses (Pleurozium schreberi (Willd. ex Brid.) Mitt.) as bioindicators of the expressway influence on forest ecosystems. Atmosphere 2024, 15, 971. [Google Scholar] [CrossRef]
- Safa, M.A.T.; Koohestani, H. Green synthesis of silver nanoparticles with green tea extract from silver recycling of radiographic films. Results Eng. 2024, 21, 101808. [Google Scholar] [CrossRef]
- Tuoriniemi, J.; Johnsson, A.C.J.; Holmberg, J.P.; Gustafsson, S.; Gallego-Urrea, J.A.; Olsson, E.; Hassellöv, M. Intermethod comparison of the particle size distributions of colloidal silica nanoparticles. Sci. Technol. Adv. Mater. 2014, 15, 035009. [Google Scholar] [CrossRef]
- Urcan, A.C.; Criste, A.D.; Szanto, K.I.; Ștefan, R.; Zahan, M.; Muscă, A.S.; Focsan, M.; Burtescu, R.F.; Olah, N.K. Antimicrobial and Antiproliferative Activity of Green Synthesized Silver Nanoparticles Using Bee Bread Extracts. Pharmaceutics 2023, 15, 1797. [Google Scholar] [CrossRef] [PubMed]
- Padmanabhan, P.; Cheema, A.; Paliyath, G.; Caballero, B.; Finglas, P.M.; Toldrá, F. Berries and Related Fruits. In Encyclopedia of Food and Health; Academic Press: Oxford, UK, 2016; Volume 60, pp. 364–371. [Google Scholar]
- Zuorro, A.; Iannone, A.; Natali, S.; Lavecchia, R. Green synthesis of silver nanoparticles using bilberry and red currant waste extracts. Processes 2019, 7, 193. [Google Scholar] [CrossRef]
- Răut, I.; Constantin, M.; Șuică-Bunghez, R.; Firincă, C.; Alexandrescu, E.; Gîfu, I.C.; Doni, M.; Zamfir, L.-G.; Gurban, A.-M.; Jecu, L. Extracellular Biosynthesis, Characterization and Antimicrobial Activity of Silver Nanoparticles Synthesized by Filamentous Fungi. J. Fungi 2024, 10, 798. [Google Scholar] [CrossRef]
- Verghese, R.J.; Mathew, S.K.; David, A. Antimicrobial activity of Vitamin C demonstrated on uropathogenic Escherichia coli and Klebsiella pneumoniae. J. Curr. Res. Sci. Med. 2017, 3, 88–93. [Google Scholar]
- Abdelraheem, W.M.; Refaie, M.M.; Yousef, R.K.M.; Abd El Fatah, A.S.; Mousa, Y.M.; Rashwan, R. Assessment of antibacterial and anti-biofilm effects of vitamin C against Pseudomonas aeruginosa clinical isolates. Front. Microbiol. 2022, 13, 847449. [Google Scholar] [CrossRef]
- Lapiz-Culqui, Y.K.; Meléndez-Mori, J.B.; Tejada-Alvarado, J.J.; Cortez, D.; Huaman, E.; Zarantes, V.M.N.; Oliva, M. Study of the physicochemical characteristics, antimicrobial activity, and in vitro multiplication of wild blackberry species from the Peruvian highlands. Sci. Rep. 2024, 14, 3863. [Google Scholar] [CrossRef] [PubMed]
- Salah-Eldin, A.A.; Ibrahim, H.H.; Ali, M.R. Antimicrobial and therapeutic potentials of the blackberry extracts against Escherichia coli infection in male albino rats. J. Sci. Food Agric. 2024, 104, 7776–7787. [Google Scholar] [CrossRef] [PubMed]
- Raza, S.; Wdowiak, M.; Grotek, M.; Adamkiewicz, W.; Nikiforow, K.; Mente, P.; Paczesny, J. Enhancing the antimicrobial activity of silver nanoparticles against ESKAPE bacteria and emerging fungal pathogens by using tea extracts. Nanoscale Adv. 2023, 5, 5786–5798. [Google Scholar] [CrossRef] [PubMed]
- Loo, Y.Y.; Rukayadi, Y.; Nor-Khaizura, M.A.R.; Kuan, C.H.; Chieng, B.W.; Nishibuchi, M.; Radu, S. In vitro antimicrobial activity of green synthesized silver nanoparticles against selected gram-negative foodborne pathogens. Front. Microbiol. 2018, 9, 1555. [Google Scholar] [CrossRef]
- Duran, N.; Duran, M.; De Jesus, M.B.; Seabra, A.B.; Favaro, W.J.; Nakazato, G. Silver nanoparticles: A new view on mechanistic aspects on antimicrobial activity. Nanomed. Nanotechnol. Biol. Med. 2016, 12, 789–799. [Google Scholar] [CrossRef]
- Pal, S.; Tak, Y.K.; Song, J.M. Does the antibacterial activity of silver nanoparticles depend on the shape of the nanoparticle? A study of the gram-negative bacterium Escherichia coli. Appl. Environ. Microbiol. 2007, 73, 1712–1720. [Google Scholar] [CrossRef]
- Li, W.R.; Xie, X.B.; Shi, Q.S.; Zeng, H.Y.; Ou-Yang, Y.S.; Chen, Y.B. Antibacterial activity and mechanism of silver nanoparticles on Escherichia coli. Appl. Environ. Microbiol. 2010, 85, 1115–1122. [Google Scholar] [CrossRef]
- Ansari, M.A.; Khan, H.M.; Khan, A.A.; Ahmad, M.K.; Mahdi, A.A.; Pal, R.; Cameotra, S.S. Interaction of silver nanoparticles with Escherichia coli and their cell envelope biomolecules. J. Basic Microbiol. 2014, 54, 905–915. [Google Scholar] [CrossRef]
- Kim, J.S.; Kuk, E.; Yu, K.N.; Kim, J.H.; Park, S.J.; Lee, H.J.; Jeong, D.H.; Cho, M.H. Antimicrobial effects of silver nanoparticles. Nanomed. Nanotechnol. Biol. Med. 2007, 3, 95–101. [Google Scholar] [CrossRef]

| Miller Indexes (hkl) | (111) | (200) | (220) | (311) |
|---|---|---|---|---|
| AgNP–lemon | ||||
| 2 θ (°) | 38.15 | 44.38 | 64.54 | 77.41 |
| AgNP–green tea | ||||
| 2 θ (°) | 38.16 | - | 64.56 | 77.49 |
| AgNP–blueberry | ||||
| 2 θ (°) | 38.15 | 44.35 | 64.53 | 77.45 |
| AgNP–blackberry | ||||
| 2 θ (°) | 38.16 | 44.32 | 64.50 | 77.43 |
Disclaimer/Publisher’s Note: The statements, opinions and data contained in all publications are solely those of the individual author(s) and contributor(s) and not of MDPI and/or the editor(s). MDPI and/or the editor(s) disclaim responsibility for any injury to people or property resulting from any ideas, methods, instructions or products referred to in the content. |
© 2025 by the authors. Licensee MDPI, Basel, Switzerland. This article is an open access article distributed under the terms and conditions of the Creative Commons Attribution (CC BY) license (https://creativecommons.org/licenses/by/4.0/).
Share and Cite
Plesnicute, R.; Rimbu, C.; Oprica, L.; Herea, D.; Motrescu, I.; Luca, D.; Creanga, D.; Grigore, M.-N. Eco-Friendly Synthesis of Silver Nanoparticles with Significant Antimicrobial Activity for Sustainable Applications. Sustainability 2025, 17, 5321. https://doi.org/10.3390/su17125321
Plesnicute R, Rimbu C, Oprica L, Herea D, Motrescu I, Luca D, Creanga D, Grigore M-N. Eco-Friendly Synthesis of Silver Nanoparticles with Significant Antimicrobial Activity for Sustainable Applications. Sustainability. 2025; 17(12):5321. https://doi.org/10.3390/su17125321
Chicago/Turabian StylePlesnicute, Ramona, Cristina Rimbu, Lăcrămioara Oprica, Daniel Herea, Iuliana Motrescu, Delia Luca, Dorina Creanga, and Marius-Nicusor Grigore. 2025. "Eco-Friendly Synthesis of Silver Nanoparticles with Significant Antimicrobial Activity for Sustainable Applications" Sustainability 17, no. 12: 5321. https://doi.org/10.3390/su17125321
APA StylePlesnicute, R., Rimbu, C., Oprica, L., Herea, D., Motrescu, I., Luca, D., Creanga, D., & Grigore, M.-N. (2025). Eco-Friendly Synthesis of Silver Nanoparticles with Significant Antimicrobial Activity for Sustainable Applications. Sustainability, 17(12), 5321. https://doi.org/10.3390/su17125321

